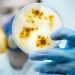
Клуб “Здрав живот и холистично здраве” представя следващата актуална тема –  инфекцията

На 10 юли в Министерството на образованието и науката се състоя връчването на официалните заповеди, с които се одобряват всички синодални учебници по „Религия-Християнство-Православие“ от 1-ви до 5-и клас включително. Учебниците на българската православна църква се включват в списъка на МОН с познавателните книжки, учебниците и учебните комплекти, които според наредба на министерството от 2017 г., могат да се използват в системата на училищното образование. Новите синодални учебници от 1-ви до 5-и клас също така са много добър помощник за занимания в семейството и в църковните училища при храмовете. По решение на Светия синод, учебниците ще бъдат раздавани безплатно на децата, които изучават „Религия-Християнство-Православие“ в светските и църковните училища. По заявки готовите и одобрени учебници ще бъдат разпространени в началните и средните училища, както и в епархиите за предстоящата 2020-2021 година.
В първи клас, когато децата учат буквите от азбуката, се разяснява, че Божието име е свято. Затова е важно децата да знаят какво точно означава то и как да го изписват правилно – с две букви „и“ – Иисус, което значи Спасител. Това е виждането на Светия синод как най-невръстните ученици да бъдат въведени в изучаването на религия.
Религия ще се учи във факултативните или задължително избираемите часове, обясни шефката на дирекция „Учебници и училищна документация“ в МОН Пенка Иванова.
В учебника за втори клас има красиви картинки, на които децата да посочат постните храни, с които подреждаме трапезата на Бъдни вечер. Има и кръстословица, в която да открият имената на библейските личности и местата, свързани с Рождество Христово. Третокласниците трябва да разберат разликата между вяра и суеверие. На децата се обяснява защо вярата в Бога ни прави уверени, силни и смели, а суеверията – неуверени, слаби и страхливи. По какво иконата се различава от снимката и художествения портрет се обяснява в четвърти клас. Учебникът е богато илюстриран с икони на водещи български иконописци. Предвиждат се упражнения с практически дейности върху десетте Божи заповеди и детската съвест – среща на любовта на Бога към нас и нашата любов към Бога и ближните.
В пети клас се изяснява значението на свещенството и монашеството като вид подвиг в служение на обществото. Разказва се за големите български манастири като огнища на вяра и духовност. Изяснява се същността на молитвата – разговор, в който се доближаваме до Бога, както разговорът с другите хора ни помага да ги разберем по-добре и да ги опознаем. Общуването е потребност на всеки човек, а общуването в любов и вяра е най-висше и най-добродетелно, ще учат децата.
Децата в първи клас, които ще учат ислям, трябва да знаят, че Аллах е единственият създател и Мохамед е пратеник, избран от Аллаах.
За първи път от над 70 години ще имаме учебници по религия и по тях ще се учи от началото на учебната 2020-2021 година, отбеляза министърът на образованието Красимир Вълчев.